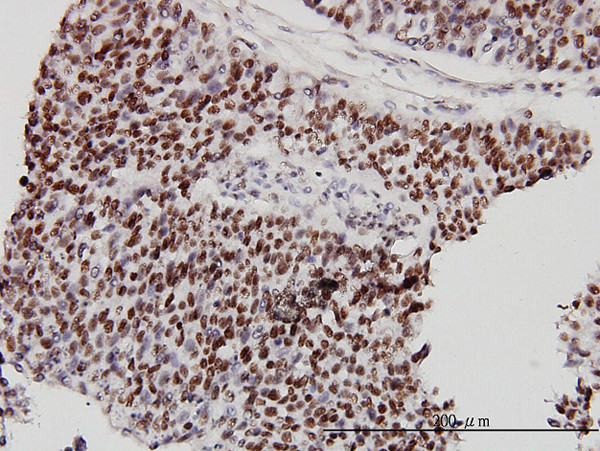
CHD4 Antibody in Immunohistochemistry (Paraffin) (IHC (P))

Search
Abnova
CHD4 Monoclonal Antibody (4H4)
{{$productOrderCtrl.translations['antibody.pdp.commerceCard.promotion.promotions']}}
{{$productOrderCtrl.translations['antibody.pdp.commerceCard.promotion.viewpromo']}}
{{$productOrderCtrl.translations['antibody.pdp.commerceCard.promotion.promocode']}}: {{promo.promoCode}} {{promo.promoTitle}} {{promo.promoDescription}}. {{$productOrderCtrl.translations['antibody.pdp.commerceCard.promotion.learnmore']}}
产品信息
H00001108-M01
种属反应
宿主/亚型
分类
类型
克隆号
抗原
偶联物
形式
浓度
纯化类型
保存液
内含物
保存条件
运输条件
产品详细信息
Sequence of this protein is as follows: ETEPKGAADV EKVEEKSAID LTPIVVEDKE EKKEEEEKKE VMLQNGETPK DLNDEKQKKN IKQRFMFNIA DGGFTELHSL WQNEERAATV TKKTYEIWH
靶标信息
The product of this gene belongs to the SNF2/RAD54 helicase family. It represents the main component of the nucleosome remodeling and deacetylase complex and plays an important role in epigenetic transcriptional repression. Patients with dermatomyositis develop antibodies against this protein.
仅用于科研。不用于诊断过程。未经明确授权不得转售。
篇参考文献 (0)
生物信息学
蛋白别名: ATP-dependent helicase CHD4; CHD-4; Chromodomain-helicase-DNA-binding protein 4; Mi-2 autoantigen 218 kDa protein; Mi2-beta; MI2B
基因别名: CHD-4; CHD4; Mi-2b; Mi2-BETA
UniProt ID: (Human) Q14839
Entrez Gene ID: (Human) 1108